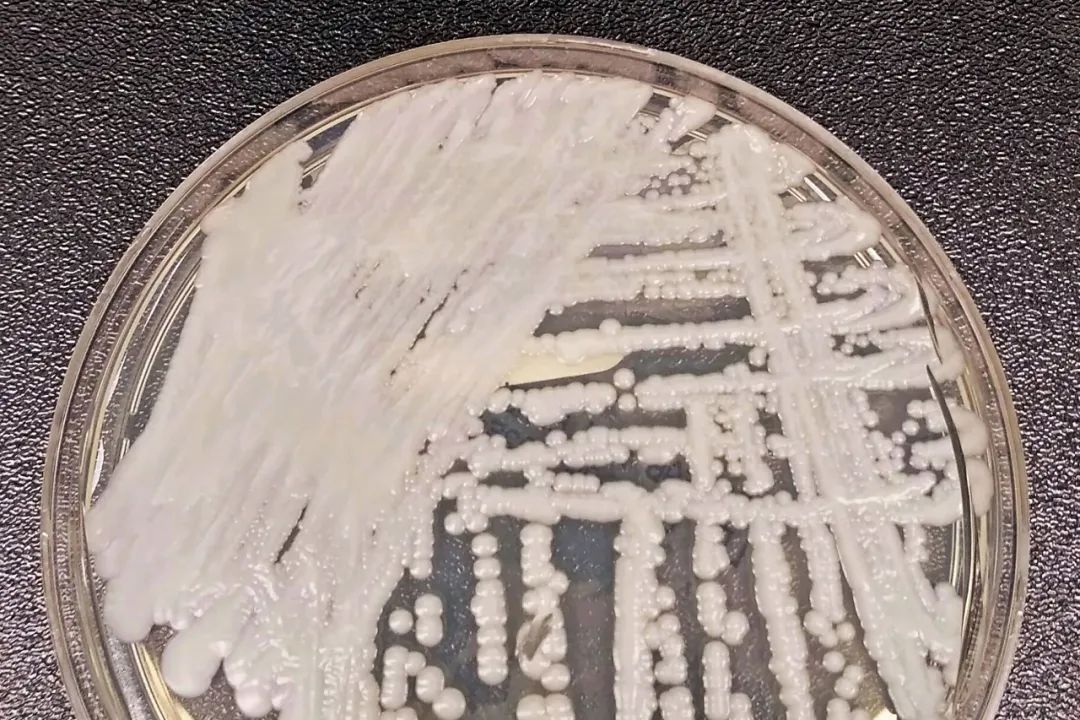

微信扫一扫

据调查,自2025年1月至3月20日,该院已确诊13例 Candida auris 感染病例,其中12例未发展为感染,仅1名73岁老年患者出现感染症状。医院表示,该患者死于手术并发症,而非因真菌感染直接致死。
HSPE在一份声明中证实了该名老年患者的病例,并表示已于1月2日首次发现 Candida auris 感染。医院立即向国家卫生监督局(Anvisa)报告,并采取了包括隔离患者、加强环境清洁以及对医护人员进行培训等防控措施。此外,医院将在未来六个月内,每月进行一次筛查检测,并与Anvisa保持每周沟通,汇报防控情况。然而,3月25日,该院医院感染委员会专家Thaís Guimarães在巴西圣保罗感染病学学会(SPI)举办的 Candida auris 线上研讨会上透露,该院已确认13例感染病例,并成为圣保罗市首个报告该真菌疫情的医院。
巴西圣保罗感染病学学会(SPI)主任、圣保罗联邦大学(Unifesp)感染病学教授Eduardo Medeiros指出,Candida auris 主要感染住院患者,尤其是重症监护室(ICU)患者,如接受化疗、安装中心静脉导管或进行复杂医疗操作的病人。
不同于其他真菌感染,Candida auris 可长期存活于医疗设备及环境表面(如输液管、病床护栏、体温计等),且对大多数医院常用消毒剂及抗真菌药物具耐药性,使得清除难度极大。此外,巴西目前仅有少数实验室具备检测该真菌的能力,这也加剧了防控挑战。
Medeiros警示称,该真菌自2020年起在巴西出现,全球感染死亡率约为40%。目前,除HSPE外,伯南布哥州一家医院也报告了4例感染病例。自2020年12月巴西确诊首例 Candida auris 感染以来,全国累计确诊114例,其中76例发生在伯南布哥州医院。
圣保罗州首例感染病例则发生在坎皮纳斯市,一名早产婴儿在Hospital da Mulher Prof. Dr. José Aristodemo Pinotti-Caism/Unicamp出生后确诊。
针对 Candida auris 传播风险,Medeiros表示,一旦发现感染病例,医院必须立即隔离患者,并进行密切接触者筛查。与感染者同房超过72小时的患者需接受三次检测,以确认是否被感染。在筛查结果未出炉前,这些密切接触者也需采取隔离措施。
Medeiros强调,巴西本已面临耐药细菌带来的公共卫生挑战,而超级真菌 Candida auris 的扩散将加剧医院感染控制压力。他呼吁全国医疗系统加强防控,避免该真菌在巴西进一步传播。